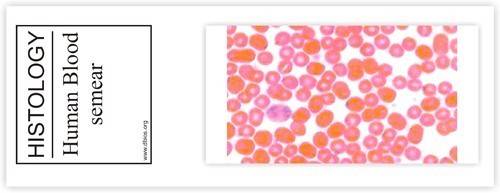

- HOME
- ABOUT US
- Contact Us
- LABORATORY GLASSWARE
- ANALYTICAL LABORATORY BENCHTOP INSTRUMENTS
- PLASTICWARE
- RUBBERWARE
- METALWARE
- LIQUID HANDLING
- WATER DISTILLATION
- LAB ESSENTIALS
- QUARTZ GLASSWARES
- Adapter
- Stoppers
- Test Tubes
- Tube Centrifuge
- Utility Sets
- Vials
- Volumetric Flask
- Automatic Burette
- Beaker
- Bottles
- Burette
- Columns
- Condensers
- Conical Flask
- Crucibles
- Cylinders
- Dessicators
- Dishes
- Disposable Culture Tubes
- Disposable Glassware
- Dissolution Vessel
- Distillation
- Extraction Apparatus
- Filtration Assembly
- Funnels
- Joints
- Pasteur Pipette
- Petri Dishes
- Pipettes
- Reagent Bottles
- Stopcocks
- DIGITAL OVERHEAD STIRRER
- HEATING MANTLE
- HOTPLATE WITH MAGNETIC STIRRER
- INCUBATOR SHAKER
- MAGNETIC STRIRRER
- MINI CENTRIFUGE
- MULTI POSITION STIRRER
- ORBITAL SHAKER
- ROLLER MIXER
- SHAKERS
- BEAKER PLASTIC
- BOX
- FLASKS PLASTIC
- HOSE CONNECTION
- PLASTIC BOTTLE
- PLASTIC CENTRIFUGE TUBE
- PLASTIC CRYO VIAL
- PLASTIC CYLINDER
- PLASTIC FUNNEL
- RACK
- SCREW THREAD
- RUBBER ADAPTER
- RUBBER CORK
- RUBBER MAT
- RUBBER SHEETS
- RUBBER TEATS
- RUBBER TUBE SAFETY BURNER
- RUBBER TUBING STRAIGHT
- BOSS HEAD
- BURETTE CLAMP
- BURNER
- FORCEPS
- RETORT CLAMP
- RETORT RING
- RETORT STAND
- SPATULA
- BOTTLE TOP DISPENSER
- MICROPIPETTES
- PIPETTE STAND
- RELOADING TRAY
- UNIVERSAL GRADUATED TIPS
- CABINET STILL
- DOUBLE STAGE
- SINGLE STAGE
- WATER SOFTNER
- GLOVES
- PARAFILM M DISPENSER
- STIRRER
- WEIGHING SCOOPS
- NEUTRAL WATCH GLASS
- SLIDE
- CONES
- PHYSICS LAB
- BIOLOGY LAB
- COMPOSITE LAB
- Computer Lab
- Digital Language Lab
- mechanics
- Cabinet
- Fume Hood
- Chair
- Lab Stool
- Furniture Auxilliary
- physics
- Biology
- Labware & Glassware
- Chemicals
- Microscope
- Pharmacy Lab Equipment
- Lab Instruments
- Maths
- Stem Lab
- Educational Charts
- mechanics
- Thermodynamics
- Light & Optics
- Electricity & Magnetism
- Units & Measurements
- Physics Models
- Waves
- Physic Accessories
- Chemistry Lab Accessories
- Chemistry Models
- Chemistry Lab Consumables
- Biology Lab Apparatus
- Biology Lab Accessories
- Biology Models
- Specimens
- slides
- Quartzware
- Desiccators
- Other Labwares
- Chemical Kits
- Compound Microscope
- Medical Microscope
- Binocular Microscope
- Stereo Microscope
- Trinocular Microscope
- Dissecting Microscope
- Microtome
- Projection Microscope
- Microscope Accessories
- Leak Test Apparatus
- Tablet Hardness Tester
- Actophotometer
- Ampule
- Analgesiometer
- PH Meter
- Potentiometer
- Test Kits
- Spectrophotometer
- Flame Photometer
- Colorimeter
- Other Instruments
- Colony Counter
- Turbidity Meter
- TDS METER
- Math Kits